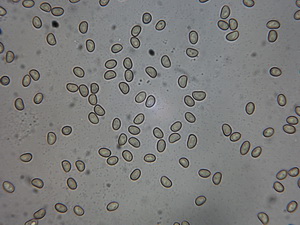

Simocybe centunculus
Simocybe centunculus (Fr.) P. Karst., Bidr. Känn. Finl. Nat. Folk 32: 420 (1879)
Simocybe centunculus (Fr.) P. Karst., Bidr. Känn. Finl. Nat. Folk 32: 420 (1879)
.
.
zuletzt gefunden: am 27.10.2021, Mönchengladbach Volksgarten, MTB 4804/2, auf altem Buchenstamm
leg. H.Bender, det. H.Bender